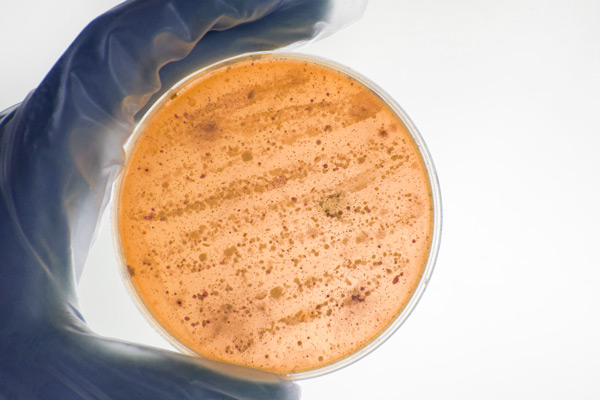
Видове дрожди и техните свойства при използването им в пивоварството

Генно-модифицирана мая: Бъдещето на бирата?
В свят, където науката непрекъснато разширява границите на възможното, дори вековни традиции като пивоварството не остават незасегнати. Един от най-вълнуващите и същевременно дискусионни аспекти в…


В свят, където науката непрекъснато разширява границите на възможното, дори вековни традиции като пивоварството не остават незасегнати. Един от най-вълнуващите и същевременно дискусионни аспекти в…
Дрождите са жизненоважна съставка в процеса на пивоварство, отговорна за ферментацията, която превръща захарите в алкохол и въглероден диоксид. Те не само придават на бирата…